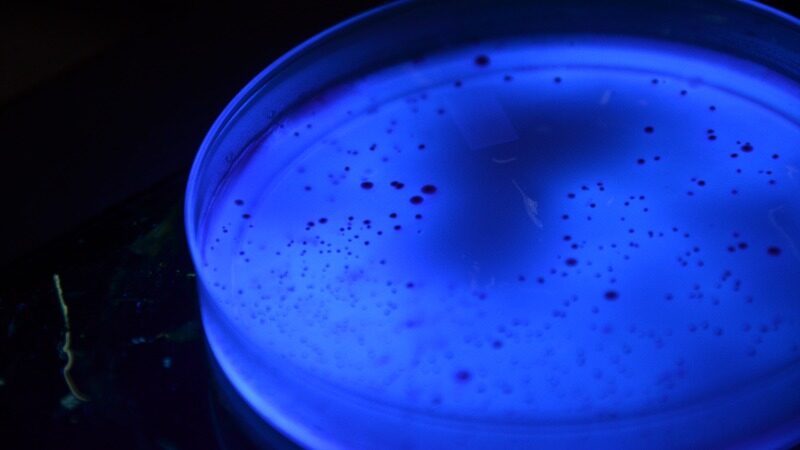

Services
Bacteriology
Isolation and identification of microbial species in the poultry industry and beyond.
Our bacteriology services provide precise isolation and identification of aerobic, anaerobic, and micro‑aerophilic microorganisms. While widely used in poultry diagnostics, these methods are equally applicable to general veterinary and environmental samples.
SMT VET provide an extensive range of methodologies, such as:
- Aerobic Bacterial Isolation
- Micro‑aerophilic Bacterial Isolation
- Anaerobic Bacterial Isolation
- Bacterial Identification (Maldi)
- Yeast and Mould Identification (Maldi) (Unaccredited)
- Antimicrobial Disc Susceptibility Testing
- Minimum Inhibitory Concentration Testing (Unaccredited)

Why Choose SMT VET
Industry-Leading Speed
Results in as little as 3 days for positive release, consistently beating average turn-around times.
Trusted Accreditation
SANAS accredited and DAH approved, ensuring full compliance.
True Partnership
Nation-wide footprint with personal, expert support whenever you need it.
Get Started
Request a Quote Today
Fast, accredited testing tailored to your needs.
Our team will guide you to the right methods and provide clear turnaround times.



